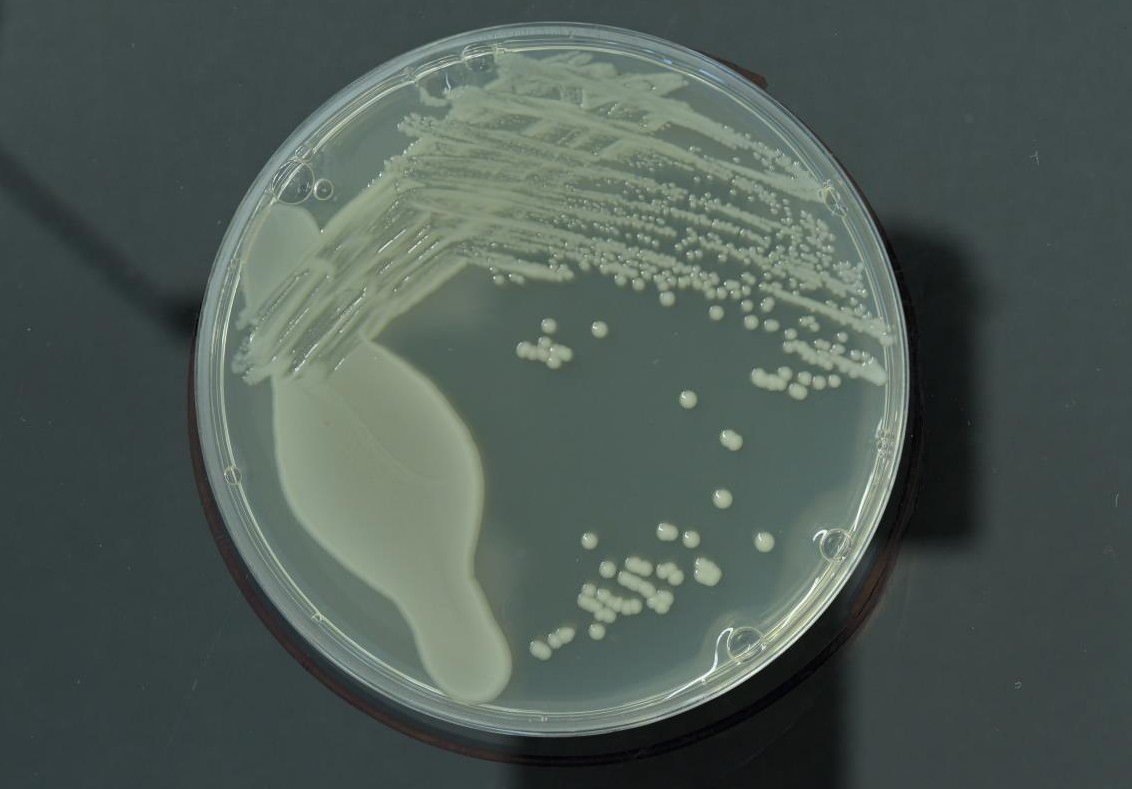
paenarthrobacter nicotinovorans

Crop not responding to nitrogen is one of the most frustrating problems in the field. You apply nitrogen, the timing looks right, and the spend is real. However, the crop still stays flat, patchy, or slow to move. At that point, the question changes. Is the field short of nitrogen, or is the crop struggling to take it up and use it properly? That is the real issue this guide explores. We will look at the most common reasons crops fail to respond, what to check first in the field, and when a foliar support tool may be worth testing.
Quick Answer
If a crop is not responding to nitrogen, the problem is not always nitrogen supply.
Very often, the crop struggles with uptake or use, not simply with how much nitrogen you applied. Cold weather, dry conditions, poor rooting, compaction, uneven soil moisture, and stress can all slow the crop down, even when nitrogen is present.
So, before adding more N, it makes sense to check what is really limiting the response. Then, if the crop still has leaf area and the ability to recover, a foliar support tool may be worth testing.

Key Facts
Main problem: the crop looks slow, patchy, or flat after nitrogen goes on.
Most common cause: poor response often comes from weak uptake or weak use, not simply low nitrogen supply.
What can slow response: cold weather, dry conditions, poor rooting, compaction, uneven moisture, or general crop stress.
What to check first: root depth, soil moisture, field variation, crop growth stage, and whether the canopy is still actively growing.
Big mistake to avoid: adding more nitrogen before checking what is really limiting the crop.
When a foliar tool may fit: when the crop still has leaf area, still has recovery potential, and needs support rather than another blanket dose of nitrogen.
Crop not responding to nitrogen: what’s really happening in the field
When a crop does not respond to nitrogen, the problem often starts before the fertiliser ever reaches the plant’s growth engine. Nitrogen may be present in the soil or already applied to the field. However, the crop still needs to take it up, move it through the plant, and turn it into growth. That is where things often slow down.
Cold weather can check root activity. Dry conditions can reduce movement in the soil and limit uptake. Compaction can stop roots exploring properly. Uneven moisture can make one part of the field move while another part stays behind. In some cases, the canopy simply does not have the energy or leaf activity to respond well. That is why “not responding to nitrogen” is often really a crop-function problem, not just a fertiliser problem. In the field, it usually looks like this:
- The canopy stays pale or flat for longer than expected.
- Growth turns stop-start after stress.
- One area pushes on, while another lags behind.
- Growth stages spread out across the same field.
- The crop looks hungry, but adding more nitrogen does not feel like a confident answer.
So, before topping up again, it helps to stop and ask a better question. Is the field truly short of nitrogen, or is the crop struggling to access and use what is already there? That is the point where diagnosis becomes more valuable than another pass.
What to check first before adding more nitrogen
Before adding more nitrogen, check whether the crop can actually use it.
- Start with the roots. If roots are shallow, restricted, or sitting in poor soil conditions, the crop may struggle even when nitrogen is present. So, dig plants from both the good and weak areas of the field and compare rooting depth, root health, and soil condition.
- Next, check moisture. Dry topsoil, uneven moisture, or a crop coming out of stress can all slow uptake. In that situation, the problem is not always a lack of nitrogen. Instead, the crop may simply lack the conditions it needs to respond.
- Then look at field variation. If one part of the field looks stronger than another, ask what changes across those areas. Soil structure, compaction, drainage, previous traffic, and organic matter can all affect how well the crop responds.
It also helps to check growth stage and canopy activity. If the crop still has active leaf area and some recovery potential, then support tools may help. However, if the crop is badly shut down, another nitrogen pass may not solve the real problem.
In practical terms, check these first:
- Root depth and root health
- Soil moisture and recent stress
- Compaction or poor soil structure
- Field variation between strong and weak patches
- Crop growth stage and active leaf area
This matters because the wrong diagnosis often leads to the wrong decision. And too often, that means adding more nitrogen when the real blocker sits somewhere else.

When a foliar tool may fit
A foliar tool may fit when the crop still has the ability to respond, but the field result still looks weak, uneven, or delayed after nitrogen timing. This is the key point: a foliar support tool makes most sense when the crop is active enough to use help, but something is still holding back a clean response. In practice, that often means:
- The crop is coming out of cold or dry stress.
- The canopy still has active leaf area.
- Nitrogen is on, but colour and pace still look uneven.
- One part of the field is moving, while another still lags behind.
- You want to test support for uptake and response before adding more bulk nitrogen.
This is where a foliar option becomes worth considering. It does not replace diagnosis. It does not replace the basics. However, it may help when the crop still has recovery potential and the leaf is the right place to act. At the same time, a foliar tool fits less well when:
- The crop is shut down in prolonged drought.
- Root damage or compaction is the real limiter.
- The main shortage is not nitrogen at all.
- The canopy is too weak or too small to respond properly.
So, the best time to use a foliar support tool is not when the crop has fully stopped. It is when the crop can still recover, but the field response still needs help.
How to test crop response properly in the field
If you want a useful answer, keep the test simple. Do not change five things at once. Instead, compare one treated strip with one untreated strip in the same field. Then keep everything else the same.
That means:
– same variety
– same nitrogen plan
-same drilling history
– same spray timing for the rest of the programme
– same field conditions as far as possible
The aim is not to build a perfect research trial. The aim is to make the result easy to read. Start by choosing a part of the field where crop response often turns patchy or uneven. Then mark out one treated strip and one control strip nearby. Next, take photos from fixed points before you spray. This gives you a clean starting record. Then go back at regular intervals and compare what you see.
The simplest things to check are:
- Canopy colour
- Crop pace
- Uniformity across the strip
- Growth stage spread
- General field appearance
Then, later in the season, check the outcome at harvest if you can. Yield, grain fill, crop quality, or even simple field notes can all help you judge whether the response was real. If you have NDVI, that is useful. However, you do not need fancy kit to run a good comparison. Photos, notes, and a clean strip layout still tell you a lot. The key is to keep the trial fair. So, do not change dose, timing, tank mix, and product choice all at once. Otherwise, you will not know what actually drove the result.
In short, the best field trial is often the cleanest one:
one strip treated, one strip not treated, and a simple record of what changed.
FAQs
Why is my crop not responding to nitrogen even though I applied it on time?
Often, the problem is uptake, not supply. Cold weather, dry conditions, poor rooting, compaction, and uneven moisture can all slow the crop down, even when nitrogen is already there. So, check roots, moisture at depth, and soil structure before assuming the field needs more N.
Should I add more nitrogen if the crop still looks pale after stress?
Not automatically. Pale leaves often follow stress even when nitrogen is present. So, fix uptake first, then feed for growth once the crop starts moving again.
When may a foliar support tool fit?
A foliar tool may fit when the crop still has active leaf area, nitrogen is already on, and the response still looks flat, patchy, or delayed. In that case, the leaf may be the right place to support the crop while it recovers.
Is BactoStym Nitro a replacement for synthetic nitrogen?
No. Use it as a support tool, not a full replacement. It may help support response and nitrogen use efficiency during stress or recovery windows, but it does not replace a wider nitrogen plan.
Should I cut nitrogen straight away if the crop looks unresponsive?
Not before you diagnose the problem properly. First, check whether the crop is struggling with uptake, rooting, moisture, or stress. Then, if you want to explore a lower-N approach, test it carefully in strips rather than changing the whole field at once.
How quickly should I see a difference?
That depends on the crop, weather, and timing. Many growers first notice changes in canopy pace, colour, or uniformity within 7–14 days. However, the best way to judge it is to measure the response rather than rely on one quick field walk.
When is the best time to spray BactoStym Nitro?
Use it when growth should be moving, but the crop still looks flat, or when stress has slowed the response. Spray in an active growth window and aim for even canopy coverage.
Can I mix BactoStym Nitro with liquid fertiliser or PPPs?
Often yes, but avoid bactericides and very harsh mixes. If in doubt, keep the programme simple or split the pass.
Does it work on cereals and oilseed rape?
Yes, and it may also fit maize, sugar beet, potatoes, peas, and soy. However, timing and crop condition matter more than the crop name on its own.
What is the best way to prove it pays?
Run one treated strip against one untreated strip. Then compare canopy pace, colour, growth stage spread, and harvest result. A simple, clean strip trial usually tells you more than guesswork.
What if one part of the field responds and another stays stuck?
Treat that as a diagnosis clue. Usually, the weaker areas have tighter structure, less moisture at depth, colder soils, or poorer rooting. So, compare those zones before blaming nitrogen alone.
Related guides (useful next reads)
- Foliar nitrogen fixing spray: full explanation, lab results, and field-trial update
- Reduce nitrogen fertiliser use: the practical plan once you fix the main uptake blockers
- BactoStym Nitro: product overview, foliar use, and key application guidance
- Soil compaction in fields: fix uptake before you add more N
- Shallow roots in crops: why uptake stalls in dry spells
- Patchy emergence in crops: win the first 10 days
Further reading
- AHDB: better estimation of soil nitrogen use efficiency in cereals and oilseed rape
Wrap up
If your crop is not responding to nitrogen, the answer is rarely “just add more”. In many cases, stress slows uptake before true shortage becomes the main issue. So, start by checking roots, moisture, soil structure, and field variation. Then, if the crop still has active leaf area and recovery potential, test a foliar support tool in a simple treated strip against a control strip. That gives you a better answer than guesswork. More importantly, it helps you diagnose the real problem before you change the whole plan.